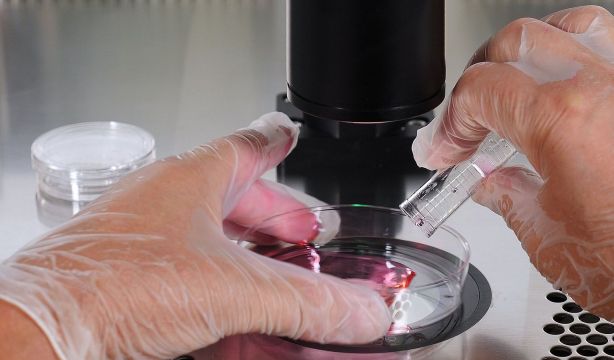
Una nueva técnica podría duplicar la tasa de embriones viables en reproducción asistida

Una nueva técnica podría duplicar la tasa de embriones viables en reproducción asistida
Hallazgo presentado en el 41º Congreso de la Sociedad Europea de Reproducción Humana y Embriología
La capital francesa reunió a expertos internacionales en fertilidad con motivo del 41º Congreso de la Sociedad Europea de Reproducción Humana y Embriología (ESHRE) y en el evento se presentó una nueva técnica que podría duplicar la tasa de embriones viables en reproducción asistida.
Este encuentro global, considerado uno de los más importantes en el ámbito de la reproducción asistida, ha servido como plataforma para la presentación de investigaciones pioneras que marcan el futuro de la medicina reproductiva.
Entre los trabajos que más interés han despertado, destaca un avance tecnológico que podría transformar el tratamiento de la infertilidad masculina: la imagen hiperespectral de espermatozoides. Se trata de una herramienta no invasiva que, mediante el uso de luz y una cámara especializada, permite identificar los espermatozoides con mayor probabilidad de generar embriones viables, sin comprometer su integridad ni alterar su viabilidad.
El estudio, titulado 'Hyperspectral imaging of single spermatozoa before ICSI predicts optimal embryo development: potential use as a non-invasive tool for sperm selection', ha sido presentado en el marco del citado congreso y propone un enfoque completamente nuevo en la selección espermática. A diferencia de los métodos convencionales que se limitan a evaluar parámetros como la cantidad, movilidad o morfología del semen, esta técnica permite generar un perfil bioquímico individual de cada espermatozoide, captando su "huella molecular".
Según explicó el doctor Nicolás Garrido, director de la Fundación IVI e investigador principal del estudio, “hasta ahora, los métodos para analizar el semen se basaban en parámetros básicos como cantidad, movilidad y morfología. Las técnicas bioquímicas más profundas requerían destruir los espermatozoides para obtener resultados, lo que las hacía inaplicables en la práctica clínica”.
Uno de los aspectos más destacados del hallazgo es su impacto potencial en la tasa de formación de blastocistos viables, que podría duplicarse gracias a una selección más precisa de los gametos masculinos. Esto supondría una mejora en casos de baja respuesta ovárica o mala calidad embrionaria, donde cada intento cuenta.
“Mientras que las técnicas actuales de selección embrionaria solo permiten decidir qué embrión transferir primero, esta tecnología puede influir desde el inicio, aumentando el número de embriones viables desde el proceso de fecundación”, añade el Dr. Garrido. Esta precisión abre nuevas oportunidades para personalizar aún más los tratamientos y maximizar las posibilidades de éxito, especialmente en pacientes de mal pronóstico.
Además, la técnica destaca por su escalabilidad y facilidad de implementación en laboratorios, gracias a la simplicidad de los equipos necesarios y a su bajo coste relativo, lo que podría facilitar su adopción generalizada en clínicas de reproducción asistida. Con este avance, la infertilidad masculina -tradicionalmente menos explorada que la femenina- se posiciona en el centro de la innovación, marcando un nuevo horizonte en la medicina reproductiva basada en precisión, eficiencia y tecnología no invasiva.
